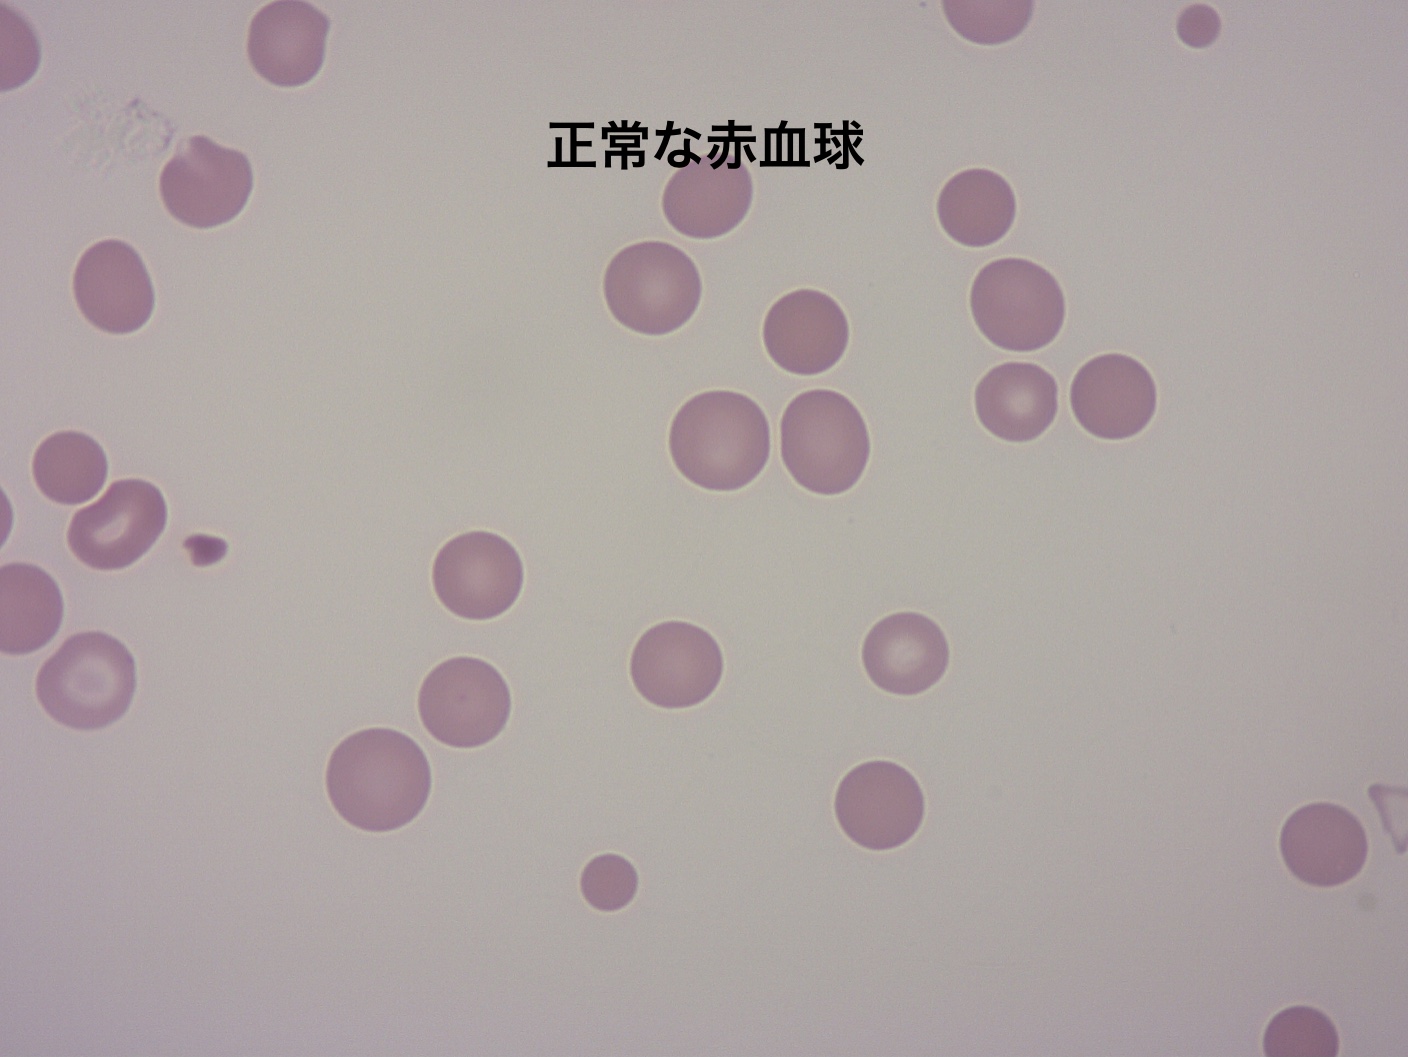
正常な赤血球
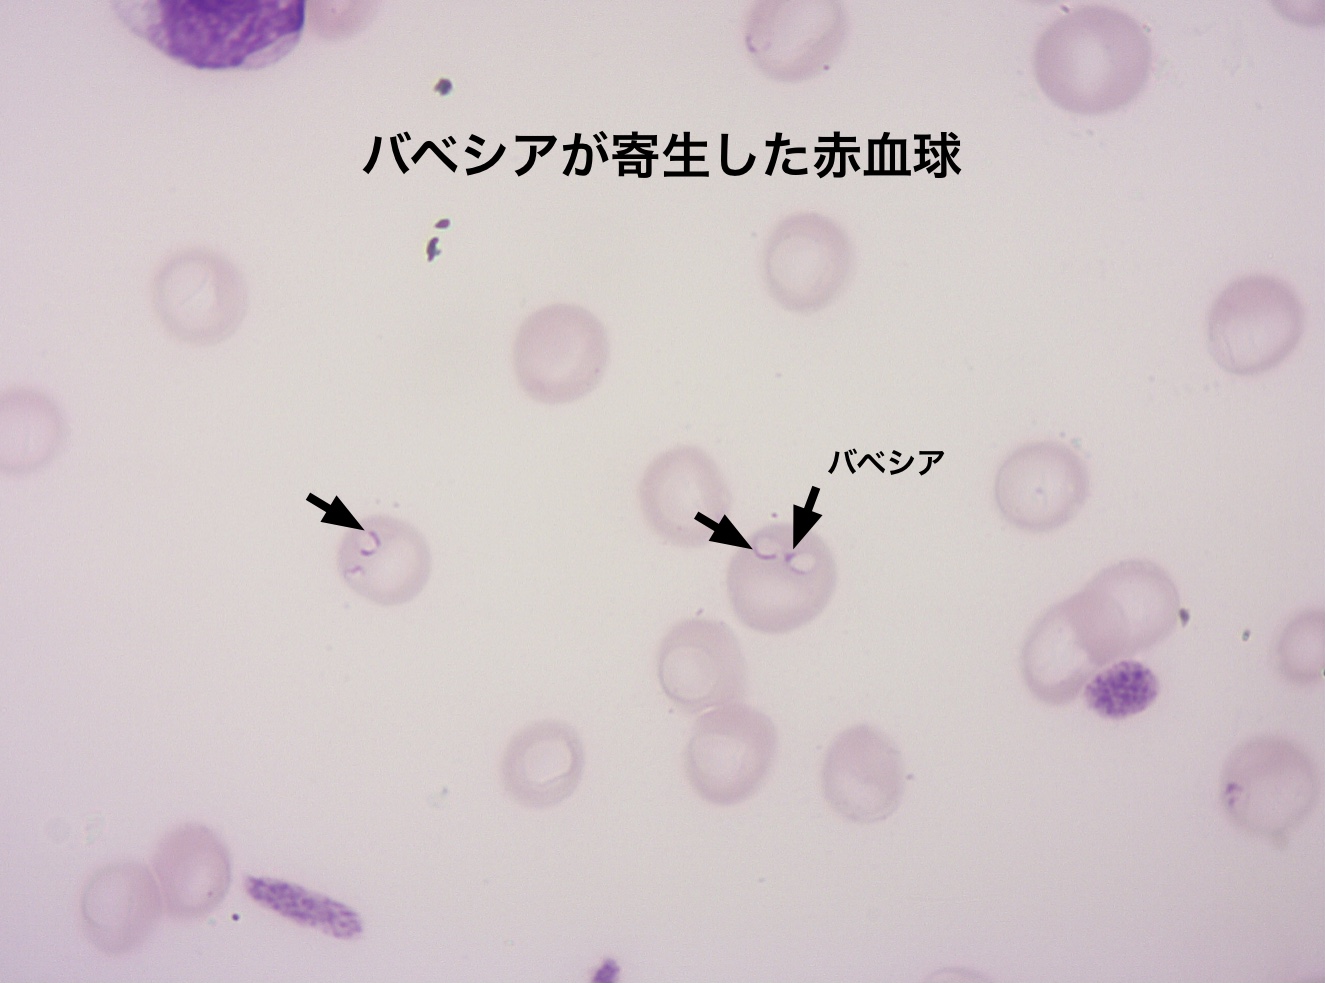
バベシアが寄生した赤血球

みなさんこんにちは。看護師の鈴木です。
各地で桜の開花発表がされており福岡もまだ満開とまでは
いきませんが、だいぶ花が咲き進んでいます。
今日はこの暖かくなるこの時期から爆発的に増えるマダニ
についてお話しします。
すわ動物病院のブログでは何度かノミ・マダニについて
お話ししてきました。
福岡県では5月からフィラリアの予防も始まるため、
みなさんだんだんと
「予防しないといけない季節が来たな」という感覚では
ないかと思います。
今日はより詳しくマダニについてやマダニから感染する
病気についてお話しします。
マダニの何が怖いの?
ここ数年で飼い主様の予防意識がかなり高くなってきています。
みなさん、予防を行う理由として
「マダニから感染する病気の予防」というよりは
「虫がつくのが嫌」というのが1番の理由かなと思います。
実際、愛犬・愛猫に虫が寄生し増殖するのは気持ちの良い
ものではありません。
しかし、マダニが寄生することで本当に怖いのは
マダニが媒介する病気です。
マダニが媒介する病気で特に怖い病気として2つ
「バベシア症」「重症熱性血小板減少症(SFTS)」
という病気があります。
何度かマダニが媒介する病気については当院のブログでも
お話ししたことがあり、
特に、重症熱性血小板減少症(SFTS)については
啓発ポスターなどをペットショップやドッグランなどでも
目にしたことがあるのではないでしょうか。
①バベシア症
バベシア症とは、バベシアという虫が赤血球に寄生する
ことで赤血球を破壊し重度の貧血を起こす病気です。
バベシアはマダニが媒介する寄生虫で、マダニが寄生し
吸血する際に体内へ侵入します。

これは顕微鏡で1000倍にして観察した正常な赤血球と
バベジアが寄生した赤血球です。
矢印で示している赤血球内が白くぬけ辺縁の一部が紫に
染まったものがバベシアです。
「これが虫?」と言いたくなるほどの大きさ・形をしています。
バベシア症は主に元気食欲低下・尿が濃くなる・貧血により
歯茎や舌が白くなるなどの症状が出ます。
バベシア症は治らない
バベシア症は一度感染すると、治療を行っても完全に
体内からバベシアを排除することは難しく
生涯にわたり保虫したままとなります。
治療を行い症状が無くなっても、大きな病気の治療
(外科手術含む)や免疫が低下した時、脾臓摘出などの
何らかのきっかけにより症状が再度現れる可能性があり、
その都度治療を行なっていくようになります。
②重症熱性血小板減少症(SFTS)
重症熱性血小板減少症(SFTS)はマダニが媒介する、
ウイルスによる感染症です。
日本では2013年に初めて海外渡航歴のないヒトがSFTSに
かかっていたことが報告さた比較的新しいウイルスです。
SFTSはマダニを介してヒトや動物に感染しますが、
感染した動物からヒトへの感染も報告されている
人獣共通感染症(ズーノーシス)です。
SFTSはヒトでは発熱・食欲不振・嘔吐下痢・腹痛、
ネコでは食欲不振・元気消失・嘔吐・黄疸、
イヌでは食欲不振・元気消失・嘔吐・下痢などの症状が出ます。
ネコはヒトやイヌとは異なり、黄疸が見られるのが特徴的です。
SFTSは、致死率が
【ヒト】27%(日本のSFTS患者において)
【ネコ】60%、
【イヌ】40%(症例数が少ないためあくまで参考)
という報告があります。
国内での SFTS発症ネコ・イヌが認められた地域
SFTSは国内では主に西日本を中心に発生しています。
発生頻度として、2021年6月30日時点で
【ネコ】370頭 【イヌ】19頭です。

国立感染研究所HP「感染症発生動向調査で届けられたSFTS症例の概要」より引用

国立感染研究所HP「感染症発生動向調査で届けられたSFTS症例の概要」より引用
この月別の発生頭数のグラフを見ても分かるとおり、
この暖かくなりマダニが爆発的に増える3月・4月以降が
圧倒的にSFTSの発生頭数が多いことが分かります。
また、イヌに比べてネコでの発生が明らかに高く、
動物園のチーター2頭の発症も報告されており
ネコ科動物の感受性が高いと考えられています。
SFTSの感染経路
SFTSがここまで大きな問題になる理由のひとつが
マダニからヒトやイヌ・ネコへ感染するだけでなく、
SFTSを発症したイヌやネコと接触した飼い主や獣医師や
看護師が感染し発症した事例が複数確認されているからです。
SFTSのヒトへの感染経路


国立感染研究所HP「感染症発生動向調査で届けられたSFTS症例の概要」より引用
SFTSは感染動物の血液、体液(涙や唾液)、排泄物、
嘔吐物にウイルスが高濃度に含まれています。
これらが、皮膚の微小な傷や粘膜を介して侵入する可能性
があるため、動物病院ではSFTS疑いのイヌ・ネコが来院
または入院した際には感染防御のために
マスク、ゴーグル(またはフェイスシールド)、ガウンの
着用が様々なセミナーや学会で啓発されている程
気をつけなければいけない病気です。
1番の予防はマダニ駆虫薬
【バベシア症】【重症熱性血小板減少症(SFTS)】
に対して、1番の予防策はマダニ駆除薬・予防薬の投与です。
現時点ではバベシア症・SFTSともに予防ができる
ワクチンはないため、マダニが吸血するのを阻止し
感染リスクを減らすことが最も効果的です。
また、駆虫薬・予防薬は適切な薬を正しい投与間隔で
確実に飲ませることで初めて効果が得られます。
今は錠剤やおやつタイプ、1錠でフィラリア・ノミ・
マダニも予防できる薬など様々な種類の駆虫薬・予防薬が
あります。
フィラリア予防は福岡県では5月からですが、ノミ・マダニ
予防は1年中の予防が必要です。
当院では、体調に問題がなければノミマダニ予防薬は
飼い主様のみのご来院でもご購入いただけます。
予防薬は基本的に体重により薬のサイズが変わってくる
ため飼い主様のみでのご来院の際は、お家で体重を
ご確認の上ご来院ください。

